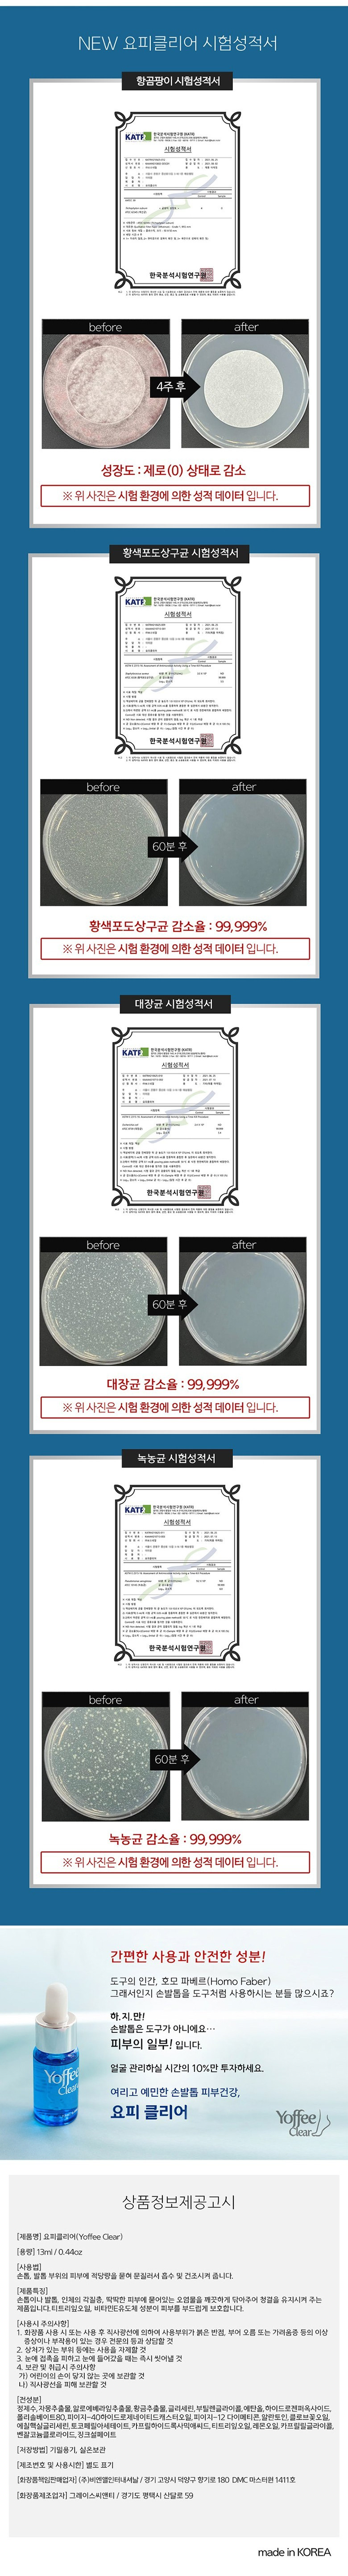

Description
Yoffee Clear Foaming Bubble Action Serum (13ml)
Expert-Approved Nail & Toenail Care Solution
From Yoffee Clear, a trusted brand by Bosnail with over 20 years of expertise, this innovative serum is designed to care for and transform problematic nails. New Yoffee Clear® combines professional-grade ingredients with an upgraded formula for stronger, healthier nails.
Say Goodbye to Nail Worries
Are your nails clean and healthy? Issues like odor, discoloration, or hard-to-reach buildup can make daily nail care challenging. Yoffee Clear provides an easy solution for healthier and stronger nails.
What is Yoffee Clear?
Yoffee Clear Foaming Bubble Action Serum is a high-concentration serum that nourishes damaged nails and restores their health. With consistent use, its bubble action gently cleanses and revitalizes nails while delivering essential nutrients.
Product Highlights:
- Over 158,000 units sold
- Trusted for 10+ years by professionals and customers alike
- Now 3x stronger with a new and improved formula
A Skincare Routine for Your Nails
Just like your skin needs care, so do your nails. Treat your nails to Yoffee Clear, a luxurious solution that cleanses, nourishes, and protects. With just one drop, experience the transformative bubble essence action.
Key Benefits
- Gentle Bubble Action: Watch foam bubbles work their magic to clean hard-to-reach areas.
- Repairs & Protects: Perfect for nails damaged by frequent nail treatments like manicures or pedicures.
- Easy Application: Includes a dual-use dropper and brush for precise, convenient application.
- Natural Ingredients: Features six premium plant-based oils for gentle yet effective care.
- Prevents Nail Issues: Protects healthy nails from exposure to communal areas like pools and baths.
- Proven Effectiveness: Loved and trusted for over a decade by thousands of loyal users.
- Safe & Lightweight: Essence-type formula feels light, even with multiple applications.
Infused with 6 Premium Plant-Based Oils
Yoffee Clear contains a blend of top-quality botanical oils that deliver deep nourishment and protection:
- Clove Flower Oil: Rich in antioxidants and provides 3x stronger results.
- Aloe Vera Leaf Extract: Hydrates and soothes.
- Lemon Oil: Brightens and refreshes.
- Grapefruit Extract: Offers natural antibacterial properties.
- Tea Tree Leaf Oil: Helps combat nail issues.
- Golden Flower Extract: Repairs and rejuvenates nails.
How to Use
- Apply 2-3 times daily to problematic areas using the dropper or brush for even coverage.
- Ensure nails are clean and dry before application for maximum absorption.
- For optimal results, pair with good nail hygiene habits.
Tips for Healthier Nails
- Keep nails clean and dry to prevent keratin buildup.
- Use slippers or sandals in wet, communal areas like pools or showers.
- Dry feet thoroughly after bathing, paying extra attention to the spaces between toes.
Why Choose New Yoffee Clear?
This improved formula was developed with input from nail care professionals and tested in salons nationwide. It features enhanced active ingredients for a 3x boost in effectiveness. The addition of clove flower oil ensures nails stay strong, healthy, and protected.
Perfect for All Nail Types
Whether you’re dealing with problem nails or simply want to maintain healthy ones, Yoffee Clear is your ultimate solution. Protect, repair, and nourish your nails at home with this bubble-action serum trusted by professionals worldwide.
Transform your nail care routine today with Yoffee Clear Foaming Bubble Action Serum!

USD ($)
EUR (€)
GBP (£)
JPY (¥)
CAD (C$)
AUD (A$)
CHF (Fr)
CNY (¥)
HKD (HK$)
SGD (S$)
SEK (kr)
NOK (kr)
DKK (kr)
PLN (zł)
CZK (Kč)
THB (฿)
MYR (RM)
PHP (₱)
IDR (Rp)
INR (₹)
SAR (SR)
AED (د.إ)
TRY (₺)
BRL (R$)
MXN ($)
ZAR (R)
RUB (₽)
UAH (₴)
VND (₫)
TWD (NT$)
Kira from Roma, Italia (verified owner) –
Mentre cercavo una soluzione per le mie unghie problematiche, ho scoperto il Yoffee Clear Foaming Bubble Action Serum. Con oltre vent’anni di esperienza alle spalle, Bosnail mi ha affascinato con questa nuova formulazione che si differenzia da prodotti simili sul mercato. Non è solo efficace nel pulire ma sembra rigenerare l’unghia dall’interno verso l’esterno! Utilizzandolo ogni giorno noto la diminuzione del fastidio dovuto all’accumulo di batteri e ad un’apparenza visivamente sana ed energica. Che soddisfazione avere finalmente mani curatissime a Roma!
Natasha Belova from Berlin, Germany –
Moisey’s stubborn fungus had haunted my nails for months, but the first pump of Yoffee Clear transformed them completely. Soon enough, people around me began to ask if I switched salons.
Claudette Dubois from Paris, France –
En ce moment, mes ongles semblent rajeunis grâce à Yoffee Clear! Cette sérum bulle adoucit et élimine la saleté tout en nourrissant les ongles abîmés. Incontournable pour qui se soucie de ses mains.
Ana López from Madrid, España (verified owner) –
Desde que comencé a utilizar el Yoffee Clear Foaming Bubble Action Serum, he notado un cambio notable en la salud de mis uñas. En comparación con otros productos más tradicionales que probé anteriormente, este suero realmente penetra profundamente y elimina esa molesta acumulación bajo las uñas sin causar molestias. Sus burbujas activas son muy satisfactorias y proporcionan una sensación de frescura única. Ya no me preocupa mostrar mis manos, ya sea al llevar sandalias o simplemente disfrutando del buen clima aquí en Madrid; además ahora pueden resistir incluso actividades diarias intensivas.
Marcus Lewis from Chicago, USA –
In the heart of Chicago’s bustling scene, I recently stumbled upon Yoffee Clear Foaming Bubble Action Serum. My nails often tell tales of neglect – battling discoloration and hidden grime after too many gel applications. This serum wowed me from the get-go! Upon applying it, a gentle effervescence swirled around my neglected fingertips, lifting away layers with ease; I’ve never experienced anything quite like it. Unlike previous products that left residue or an overpowering scent reminiscent of harsh chemicals, this innovative gem felt invigorating without compromise. It offers meticulous care while reinstating a healthy glow to each nail—it’s truly changed my perspective on at-home manicures!
Anaïs Valcourt from Toulouse, France –
Éprouvé récemment, le Yoffee Clear Foaming Bubble Action Serum a littéralement changé la donne pour mes ongles. En tant qu’enthousiaste de soins des mains ici à Toulouse, où l’hydratation et la clarté sont primordiales en raison de notre climat, ce sérum se distingue par sa texture légère et sa capacité nettoyante. Mes ongles ternes ont retrouvé éclat et robustesse au bout d’une semaine seulement! Ce qui m’impressionne vraiment est son action moussante – un véritable petit moment d’évasion pendant ma routine quotidienne. Pour ceux dont les ongles souffrent à cause du vernis ou même des conditions environnementales, je ne peux que recommander vivement cette solution efficace.
Thandiwe Zungu from Durban, South Africa (verified owner) –
As someone residing in the coastal city of Durban, South Africa, where humidity plays havoc with nail health, discovering Yoffee Clear Foaming Bubble Action Serum felt revolutionary. The foaming texture envelopes my nails gently, fostering a sensation reminiscent of the ocean’s soft caress while cleaning them efficiently. Discoloration from sun exposure has noticeably diminished after regular application; it’s been delightful watching my toenails regain their original luster! This serum showcases authenticity and innovation rarely seen in beauty products here—providing holistic nourishment beyond mere surface aesthetics.
Layla Hawas from Tunis, Tunisia –
واو! منتج Yoffee Clear فعلًا غيّر حياتي. أظافري صارت أكثر صحة وتألق، ما كنت أتوقع هالنتيجة المدهشة! جربته من أسبوعين ودايمًا أحسّ إنه عنايتي بها الحالا مثل إنعاش لهم.
Thandeka Molefe from Johannesburg, South Africa –
Yoffee Clear revitalized my nails remarkably! The foaming action effortlessly cleaned stubborn buildup, and within weeks, I noticed reduced discoloration. Highly recommend for any nail care enthusiast!
Emily from Toronto, Canada –
I love this serum! My nails have improved significantly after using it for just a couple of weeks. The foaming action makes application fun and effective.